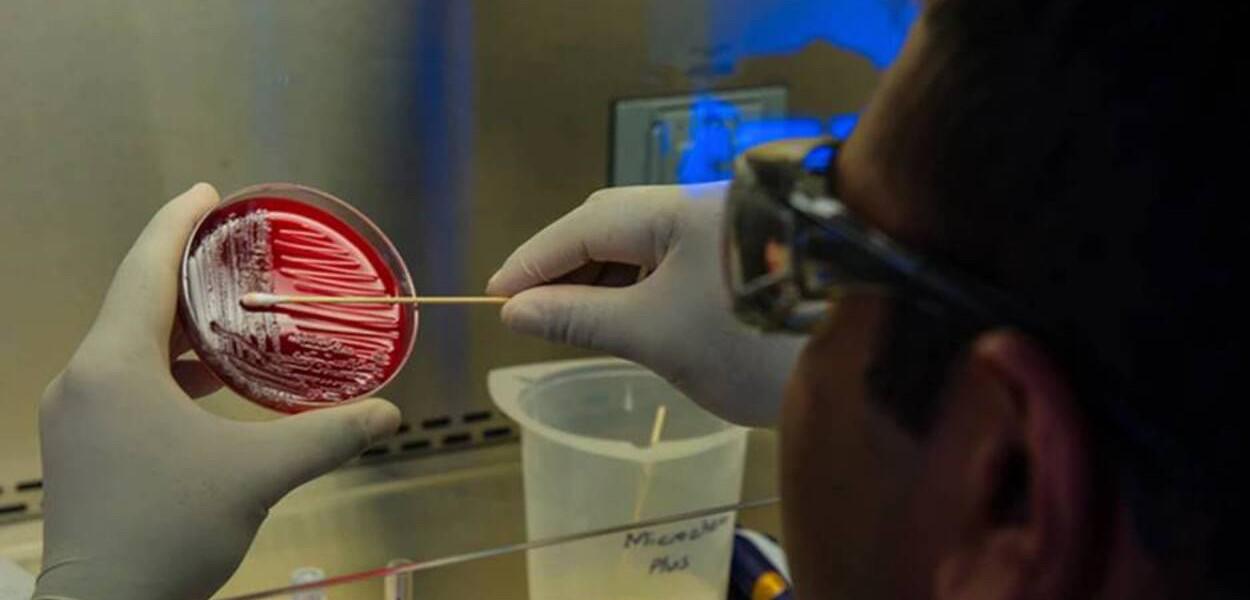

Estudo sugere que tratamento inalável pode amenizar casos mais graves de Covid-19
O medicamento SNG001 usa proteína natural e deve revolucionar a maneira como pacientes hospitalizados são tratados
✅ Receba as notícias do Brasil 247 e da TV 247 no canal do Brasil 247 e na comunidade 247 no WhatsApp.
Jacqueline Saraiva, Metrópoles - Os resultados ainda são preliminares, mas um estudo divulgado pelo laboratório Synairgen, nesta segunda-feira (20/7), aponta que um medicamento reduziria em 79% o risco de se desenvolver uma forma grave do novo coronavírus, que causa a Covid-19.
Intitulado como SNG001, o tratamento é inalável e usa interferon beta, uma proteína natural envolvida na resposta do organismo quando invadido por vírus. O medicamento ainda vai passar por uma revisão entre pares da comunidade científica, mas pode revolucionar a maneira como a Covid-19 é tratada.
Leia mais no Metrópoles.
iBest: 247 é o melhor canal de política do Brasil no voto popularAssine o 247, apoie por Pix, inscreva-se na TV 247, no canal Cortes 247 e assista:
Comentários
Os comentários aqui postados expressam a opinião dos seus autores, responsáveis por seu teor, e não do 247